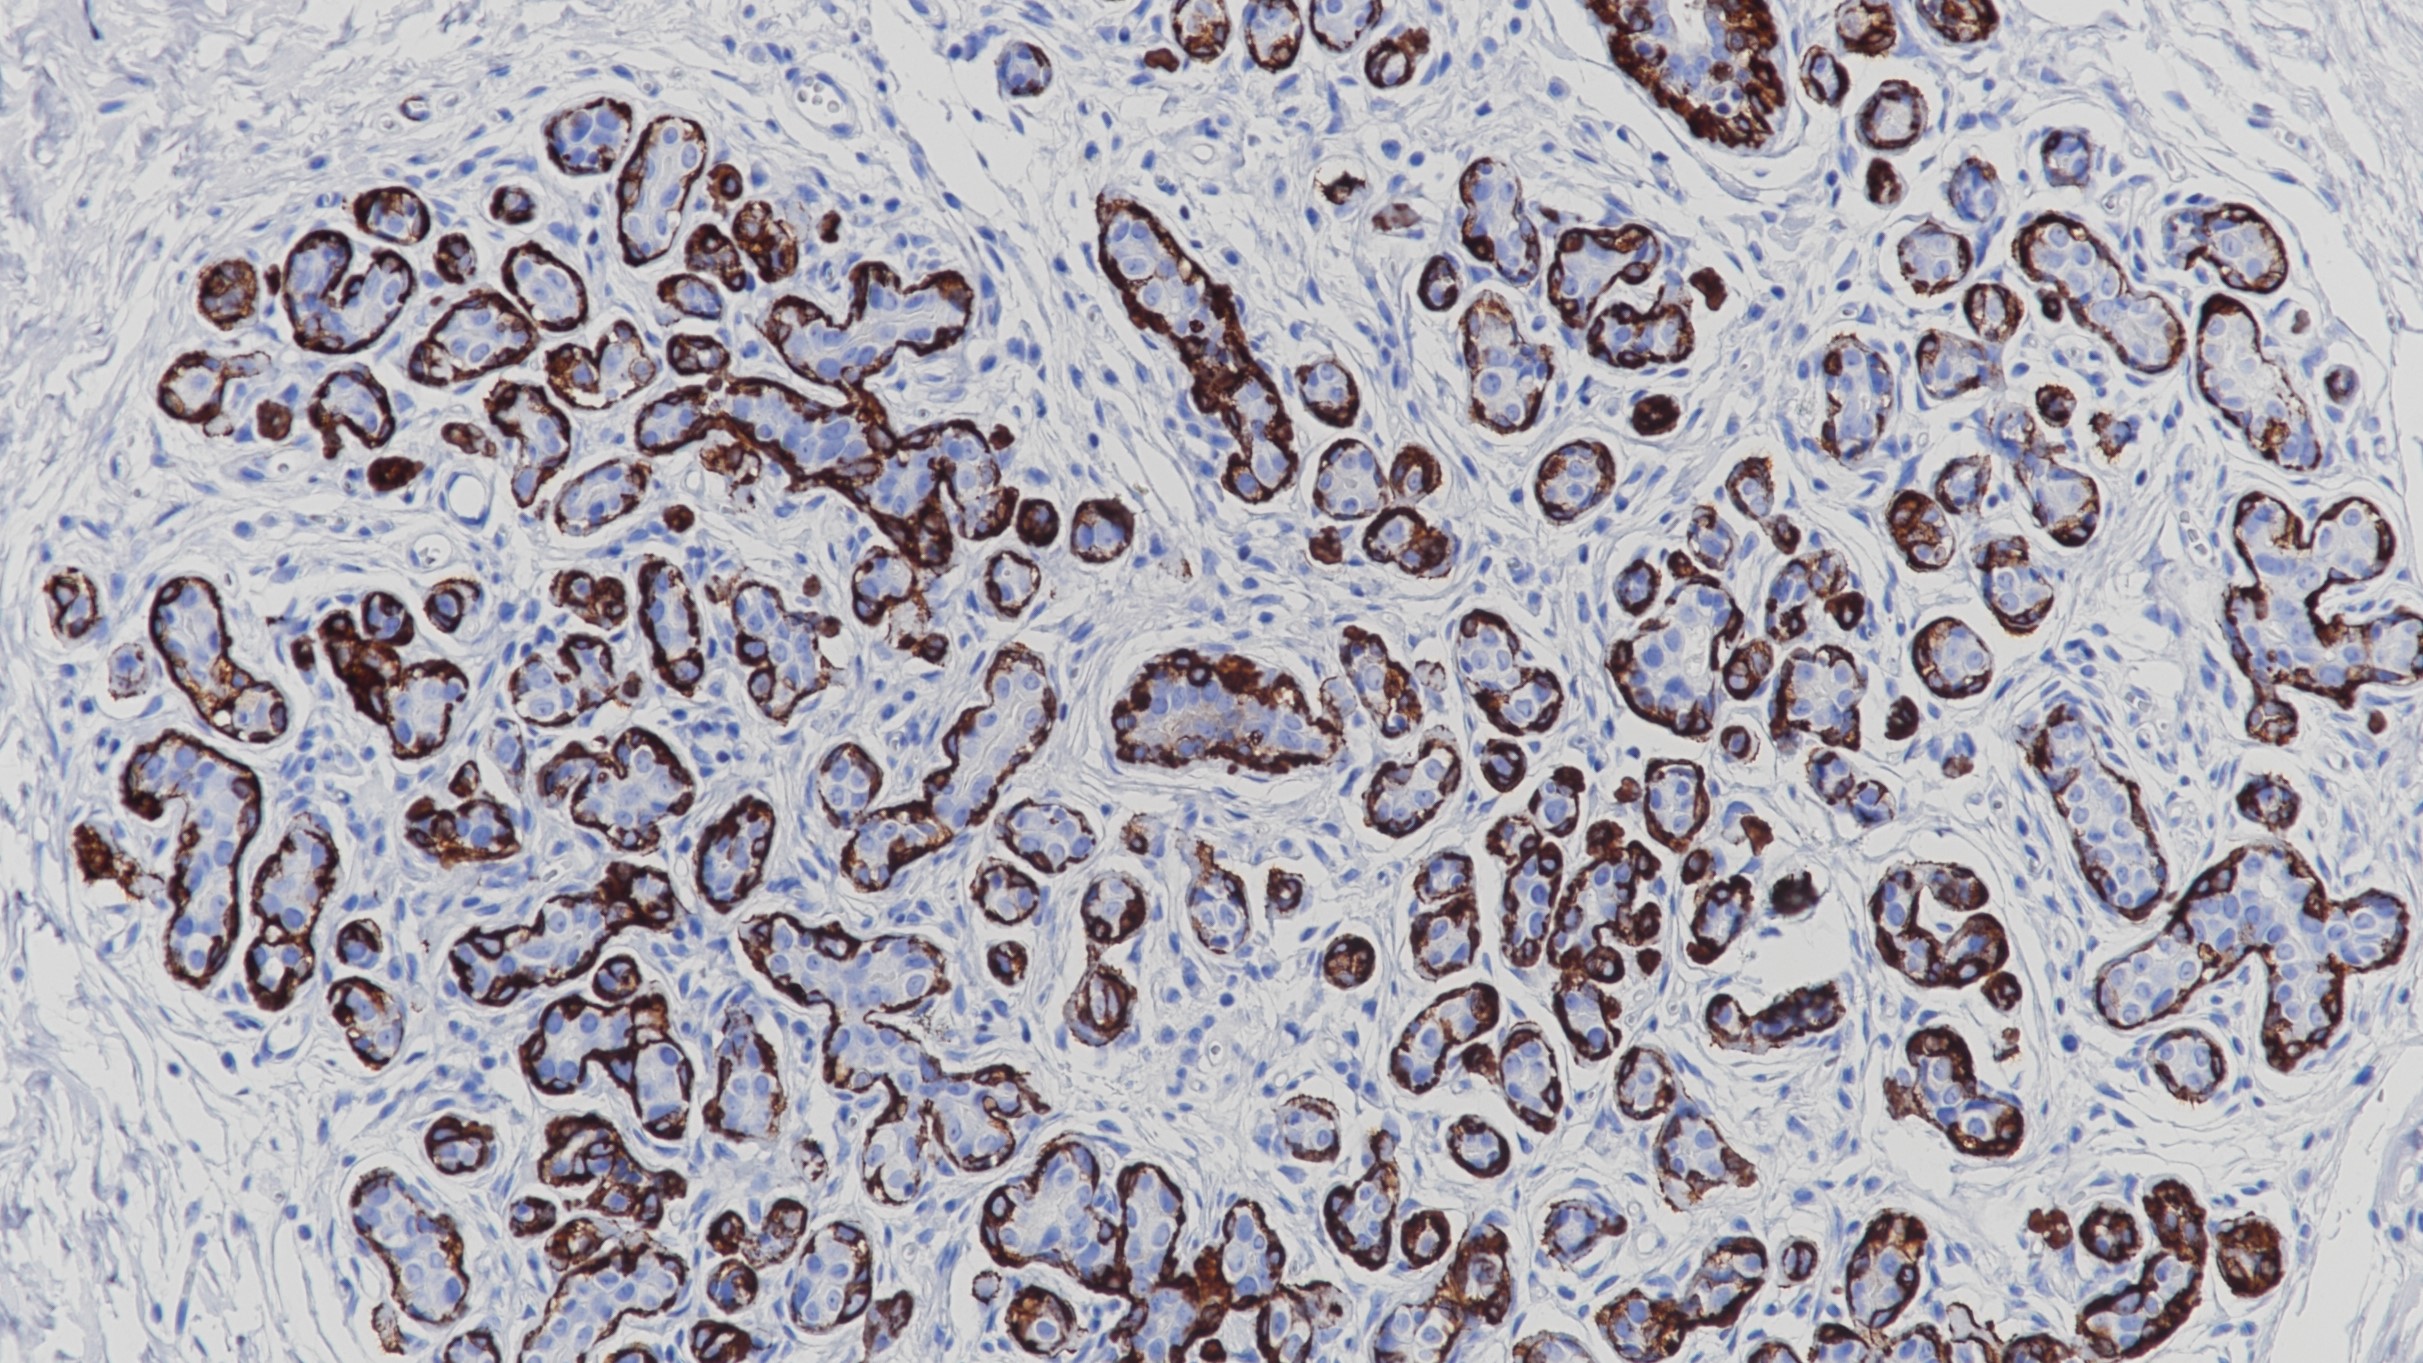
乳腺Myosin(Smooth Muscle)(BP6091)染色

1. Alhopuro P, Phichith D, Tuupanen S, et al. Unregulated Smooth-Muscle Myosin in Human Intestinal Neoplasia[J]. Proc Natl Acad Sci U S A, 2008, 105(14):5513-5518.
2. Vickaryous N, Polancoecheverry G, Morrow S, et al. Smooth-muscle myosin mutations in hereditary non-polyposis colorectal cancer syndrome[J]. British Journal of Cancer, 2008, 99(10):1726-1728.
3.中华医学会.《临床技术操作规范·病理学分册》.人民军医出版社,2004.